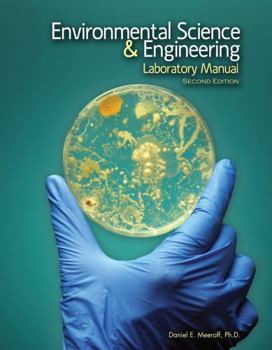
Spiral-bound Environmental Science and Engineering Laboratory Manual Book

Environmental Science and Engineering Laboratory Manual
New Second Edition Now Available! Environmental Science and Engineering Laboratory Manual provides practical hands-on experience designed to help students understand the theory and practice of... This description may be from another edition of this product.
Format:Spiral-bound
Language:English
ISBN:152494470X
ISBN13:9781524944704
Release Date:August 2017
Publisher:Kendall Hunt Publishing
Weight:0.60 lbs.
Related Subjects
Engineering Science Science & Math Science & Scientists Science & Technology TechnologyCustomer Reviews
0 rating